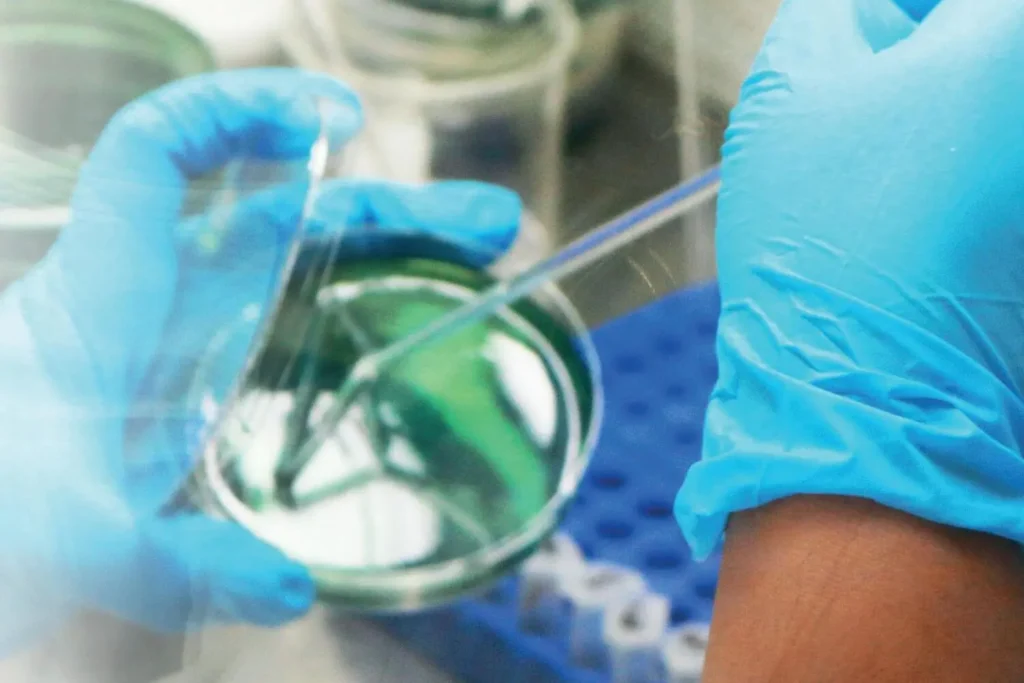
Master Bioética y Aspectos Legales 2

El Máster en Bioética y Aspectos Legales de ISEIE está orientado a formar profesionales altamente capacitados en la integración de principios éticos y normativos aplicados a contextos clínicos, de investigación y gestión sanitaria. Este programa combina el análisis de casos reales, legislación nacional e internacional y herramientas prácticas para la resolución de dilemas éticos y legales que surgen en el ejercicio diario de las profesiones de la salud y el derecho sanitario. A lo largo de la formación, los participantes desarrollan competencias sólidas para aplicar la bioética y el marco legal vigente en la atención clínica, la investigación biomédica y la administración hospitalaria.